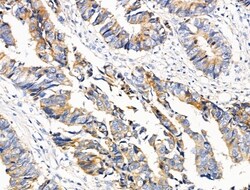
Invitrogen PCAF Polyclonal Antibody 100 &mu;L | Buy Online | Invitrogen&trade; | Fisher Scientific

missing translation for 'onlineSavingsMsg'
Learn More
Learn More
Invitrogen™ PCAF Polyclonal Antibody


Description
Antibody detects endogenous levels of total PCAF.
PCAF (histone acetyltransferase KAT2B) functions as a histone acetyltransferase (HAT) to promote transcriptional activation. It has significant histone acetyltransferase activity with core histones (H3 and H4) and nucleosome core particles. PCAF also acetylates non-histone proteins such as ACLY, PLK4, and TBX5. It inhibits cell-cycle progression and counteracts the mitogenic activity of the adenoviral oncoprotein E1A. PCAF also acts as a circadian transcriptional coactivator which enhances the activity of the circadian transcriptional activators NPAS2-ARNTL/BMAL1 and CLOCK-ARNTL/BMAL1 heterodimers. It is involved in heart and limb development by mediating acetylation of TBX5 and acetylation regulating nucleocytoplasmic shutting of TBX5.
Specifications
Specifications
| Antigen | PCAF |
| Applications | Immunohistochemistry (Paraffin), Western Blot, Immunocytochemistry |
| Classification | Polyclonal |
| Concentration | 1 mg/mL |
| Conjugate | Unconjugated |
| Formulation | PBS with 50% glycerol and 0.02% sodium azide; pH 7.4 |
| Gene | KAT2B |
| Gene Accession No. | Q92831, Q9JHD1 |
| Gene Alias | A930006P13Rik; AI461839; AW536563; CAF; CREBBP-associated factor; histone acetylase PCAF; Histone acetyltransferase KAT2B; histone acetyltransferase PCAF; K(lysine) acetyltransferase 2B; Kat2b; Lysine acetyltransferase 2B; P/ PCAF; P/CAF; P300/CBP-associated factor; Pcaf; Spermidine acetyltransferase KAT2B |
| Gene Symbols | KAT2B |
| Show More |